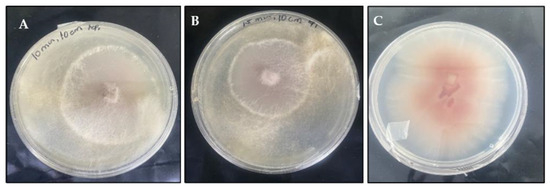

Abstract
Potatoes are a vital staple crop globally, valued for their high nutritional content and yield; however, they are highly susceptible to microbial attacks, mainly during postharvest handling and storage. One of the most important potato diseases that reduces the yield and quality of potatoes is Fusarium solani. Ultraviolet-C (UV-C) irradiation has become a potential postharvest disease control method; however, its efficacy against F. solani on potatoes is poorly understood. This study investigated the in vitro and in vivo effects of UV-C irradiation against F. solani of potatoes. UV-C light (254 nm) treatment was applied to F. solani for 5, 10, and 15 min at 10, 15, and 20 cm to evaluate the in vitro effects. The treated plates were incubated at 25 °C for seven days. UV-C treatment at a 10 cm distance for 10 and 15 min successfully inhibited F. solani mycelial growth, with the 15 min exposure showing the highest inhibition rate of 57.96%. Both treatments were selected for further screening. Subsequently, ‘Sifra’ potatoes were treated with UV-C for 10 and 15 min, and the results showed low disease incidence of 33% and 22%, respectively, compared to 96% for the untreated tubers. The scanning electron microscopy assay showed broken and shrunken mycelia, along with damaged spores of F. solani, on potatoes treated with UV-C. The findings suggest that UV-C irradiation may offer a potential alternative, environmentally friendly method to chemical fungicides for controlling postharvest F. solani of potatoes.
1. Introduction
Potatoes are globally among the most commonly consumed starchy vegetables. They are rich in carbohydrates, dietary fiber, proteins, vitamins, and minerals such as iron and potassium. However, their high moisture content and nutrient-rich composition make them particularly susceptible to postharvest losses, especially during storage [1]. Among the various factors contributing to spoilage, fungal pathogens pose a significant threat to the quality and longevity of stored potatoes [2]. Fusarium solani, the causal agent of dry rot, is one of the most destructive fungal pathogens of potatoes during storage. This disease not only reduces tuber quality and marketability but can also serve as a source of contamination during storage and handling, exacerbating losses [3]. Managing F. solani infections is particularly challenging due to its persistence and ability to survive under a wide range of environmental conditions.
F. solani has been primarily controlled by applying postharvest chemicals such as phosphorus acid, thiabendazole, mancozeb, sodium hypochlorite, calcium hypochlorite, and chlorine dioxide. These fungicides are effective against various postharvest diseases of potatoes such as pink rot, late blight, early blight, silver scurf, and black scurf [4,5]. However, the effectiveness of these treatments is often limited by the development of resistance, regulatory restrictions, and concerns over environmental and human health impacts [6,7]. These limitations underscore the urgent need for alternative or complementary strategies for postharvest disease control.
In recent years, Ultraviolet-C irradiation (UV-C,180 ± 280 nm) has gained attention as a non-chemical method for controlling postharvest pathogens [8,9,10]. UV-C irradiation is also used as a postharvest treatment to increase fruit quality and prolong the shelf life of fresh fruits and vegetables [11]. It has been reported to provide a successful control against a range of potato diseases, including dry rot and soft rot [12]. For instance, Stevens et al. [13] demonstrated that UV-C treatment (λ = 254 nm of 3.6 kJ/m2) enhanced the resistance of sweet potato roots against F. solani. UV-C treatment has also been reported to effectively reduce decay caused by most common postharvest pathogens, including Penicillium digitatum and Penicillium italicum, Botrytis cinerea, Rhizopus stolonifer, Alternaria citri and Alternaria alternata.
Furthermore, treating tomatoes with UV-C (1.3–40 kJ/m2) at 10 cm has been reported to inhibit black and gray mold, delay ripening, and extend shelf life [14]. UV-C irradiation induces resistance to pathogens by promoting the production of antimicrobial substances, particularly phenols. This effect is linked to an increase in the activity of biosynthetic enzymes, such as phenylalanine ammonia-lyase, which plays a central role in the phenylpropanoid pathway responsible for phenol synthesis. The accumulation of these phenolic compounds, known for their toxicity to various pathogens, reinforces the plant’s protective barrier and reduces susceptibility to infection [15]. In addition to promoting host resistance, UV-C radiation directly inhibits fungal pathogens through both genotoxic and oxidative mechanisms. It causes DNA damage in fungal cells by inducing the formation of pyrimidine dimers, especially thymine dimers, which disrupt DNA replication and transcription. Simultaneously, UV-C exposure generates reactive oxygen species (ROS), such as hydrogen peroxide and hydroxyl radicals, which inflict oxidative damage on cellular components, including membranes, proteins, and nucleic acids. The combined impact of DNA damage and oxidative stress compromises fungal cell viability, ultimately leading to growth inhibition and cell death [16].
Although a considerable amount of research has been conducted on the effect of UV-C on postharvest pathogens, the effect of UV-C on F. solani of potato tubers is poorly understood. This is a crucial area of research, as the food industry is shifting towards non-chemical postharvest technologies to extend the shelf life of fresh produce. While previous research has demonstrated the in vivo effectiveness of UV-C against various fungal pathogens [12,15], there is a lack of detailed studies focusing on F. solani in potato tubers under practical postharvest conditions. Moreover, the potential for fungal regrowth after UV-C treatment remains underexplored, which is crucial for determining the durability of its antifungal effect [16]. UV-C dose–response optimization in potato tubers is rarely addressed, even though it is necessary to achieve effective pathogen control without inducing tissue damage. This study aims to evaluate the efficacy of UV-C treatment in suppressing F. solani on stored potatoes and to assess its potential as a viable alternative or supplement to chemical fungicides. The mycelial growth and the disease incidence development on potatoes after UV-C treatment were also assessed. By investigating the pathogen’s response to UV-C exposure, we seek to contribute to the development of sustainable postharvest management practices for the potato industry.
2. Materials and Methods
2.1. Source of Potatoes and Pathogen (Fusarium solani)
Potatoes (cv. Sifra) were procured from Mkhondeni Fresh Produce Market, Pietermaritzburg, South Africa. A pure culture of F. solani (Accession number: PPRI 10342) used in this study was purchased from the Agricultural Research Council–Plant Protection Research Institute (ARC-PPRI), Pretoria, Roodeplaat, South Africa. The fungal culture was grown on potato dextrose agar (PDA) and stored in 30% glycerol at −80 °C for use throughout the study.
2.2. Pathogenicity Test of F. solani on Potato Cultivar Sifra
2.2.1. Preparation of Conidial Spore Suspension of F. solani
A conidial suspension of F. solani was prepared from a 14-day-old culture. Briefly, the surface of the sporulating culture was washed with sterile distilled water using a hockey stick and filtered using a cheesecloth. The hemocytometer was used to measure spore suspension concentration and adjusted to 1 × 103 and 1 × 104 conidia/mL.
2.2.2. Inoculation of Potatoes with a Spore Suspension
‘Sifra’ potatoes were sterilized with 70% ethanol for one minute and then washed with distilled water for one minute to remove dirt. Thereafter, they were placed on a paper towel to dry out at room temperature. Each potato tuber was wounded at four sites using a sterile cork borer, penetrating to a depth of approximately 3 mm and a width of 5 mm. The wounds were then inoculated with 10 µL of F. solani conidial suspensions at concentrations of 1 × 103 and 1 × 104 conidia/mL. The control potatoes were only inoculated with distilled water. The treatments were inoculated into three potatoes of four replicates per treatment. The inoculated potatoes were incubated for 21 days at 25 °C with a relative humidity of 95%. The disease incidence was evaluated every seven days until the last day of the incubation period. The concentration of F. solani conidial suspension (1 × 104), which exhibited the highest percentage of disease incidence in potatoes, was further used throughout the in vivo trials.
2.3. Investigation of the In Vitro Effects of UV-C Irradiation Against F. solani
2.3.1. Source of UV-C Light
Ultraviolet (UV) lamps (TUT, 30 W, Philips, South Africa) emitting quasi-monochromatic UV radiation at 254 nm were used. The UV-C irradiation was set at 208.2 μW/cm2, and the radiation doses were measured with a portable digital radiometer (GAL-3L, GOLDILUX).
2.3.2. In Vitro Screening of UV-C Against F. solani
A 3-day-old mycelial plug of F. solani was cut into 3 mm × 3 mm using a flame-sterilized scalpel and placed at the center of fresh PDA plates. The inoculated plates were exposed to UV-C treatment for 5 min, 10 min, and 15 min at 10 cm, 15 cm, and 20 cm distances. For control plates, PDA plates were inoculated with the pathogen and not exposed to UV-C treatment. Three replicates per treatment were used. The plates were sealed with parafilm and incubated at 25 °C. The mycelial growth of F. solani was observed and measured at 3-, 5-, and 7 days post-inoculation (dpi). The mycelial growth inhibition was calculated using the following formula:
where MGC is the average diameter of Mycelia Growth in the control sample; MGT is the average diameter of Mycelia Growth in the treated sample.
The distance that showed great performance was further used in in vitro secondary and in vivo screening.
2.4. In Vivo Screening of UV-C Against F. solani
A sample of fresh ‘Sifra’ potatoes was surface-sterilized with 70% ethanol for 1 min, rinsed in distilled water for 1 min, and allowed to dry at room temperature. Wounded potatoes were exposed to UV-C treatment for 10 and 15 min at 10 cm. After 24 h, 10 µL of F. solani conidial suspension at 1 × 104 was inoculated into UV-C-treated potatoes. For the control treatment, potatoes were not exposed to UV-C and only inoculated with a volume of 10 µL of the conidial suspension. There were three replicates, with four potatoes per replicate. The inoculated potatoes were stored in boxes properly sealed with plastic and incubated at 25 °C with 95% relative humidity for 21 days. Disease incidence was evaluated at 7, 14, and 21 days post-inoculation. The following formula was used to calculate the disease incidence:
2.5. Scanning Electron Microscopy Analysis of the Interaction Between F. solani and UV-C Irradiation In Vitro and In Vivo
Treatments that effectively suppressed F. solani in vitro and in vivo were selected for scanning electron microscopy (SEM) analysis. The samples were prepared as described in Section 2.3.2 for in vitro and Section 2.4 for in vivo studies. SEM observations were carried out after 7 days for the in vitro samples and after 14 days for the in vivo samples to evaluate the inhibition of fungal growth and spore formation. SEM imaging was performed using a Zeiss EVO LS15 microscope at the Microscopy and Microanalysis Unit, University of KwaZulu-Natal, Pietermaritzburg. Before viewing, samples were excised from both the PDA cultures and potatoes, then fixed in 3% glutaraldehyde, and washed twice with 0.05 M sodium cacodylate buffer. The samples were then dehydrated in 2 mL aliquots of different concentrations of ethanol for 1 h and thereafter dried using the Quorum K850 critical drying point dryer (CPD). The dried samples were mounted on SEM stubs using black conductive tape, coated with a sputter coater for 150 s, and viewed under the Zeiss EVO LS15 SEM.
2.6. Statistical Analysis
All experiments were set up in a completely randomized design and replicated three times. The data obtained was subjected to analysis of variance (ANOVA) using Genstat® 23rd Edition. Duncan’s Multiple Range Test (DMRT) was performed to test the significance of the mean differences obtained among the treatments at the 5% level of significance.
3. Results
3.1. Pathogenicity of F. solani on Potato Cultivar Sifra
The pathogenicity test revealed that F. solani was pathogenic to ‘Sifra’ potato tubers. There was a significant difference (p < 0.05) between the pathogen-inoculated potatoes and the control treatment (Figure 1). Potatoes inoculated with 1 × 104 spores/mL exhibited the highest disease incidence (90%) of dry rot (Figure 2A). The control potatoes exhibited the lowest dry rot disease incidence (2.08%) (Figure 2B).

Figure 1.
Fusarium dry rot incidence on ‘Sifra’ potatoes inoculated with different concentrations of Fusarium solani conidia spores compared to un-inoculated (control) potatoes at 25 °C and 95% relative humidity after 21 days. Bars with different letters are significantly different according to Duncan’s Multiple Range Test (p < 0.05).

Figure 2.
Incidence of Fusarium dry rot on ‘Sifra’ potatoes inoculated with 1 × 104 conidia/mL of F. solani (A) and un-inoculated potatoes (B) at 25 °C, 95% relative humidity after 21 days.
3.2. In Vitro Effect of UV-C Against F. solani
The 10 cm distance showed the best performance compared to the 15 cm and 20 cm distances. The highest percentage (57.96%) of inhibition of mycelial growth of F. solani was observed after a 15 min exposure to UV-C treatment (Figure 3). On the other hand, 10 and 15 min of exposure to UV-C treatment inhibited F. solani mycelial growth by more than 50% at 7 days post-inoculation (Table 1). UV-C treatment for 5 min was the least effective in inhibiting the mycelia of the pathogen. The pathogen growth reached full plate coverage in control treatments (Figure 4C).

Figure 3.
Effect of UV-C irradiation on mycelial growth of F. solani on potato dextrose agar after 7 days post-inoculation at 25 °C. Bars with different letters are significantly different according to Duncan’s Multiple Range Test (p < 0.05).

Table 1.
In vitro effect of UV-C irradiation on Fusarium solani at a 10 cm distance.
Figure 4.
Best-performing UV-C treatment of 10 min (A), 15 min (B), against Fusarium solani, and control (C) on potato dextrose agar medium at 7 days post-inoculation at 25 °C.
3.3. In Vivo Effect of UV-C Treatment Against F. solani on Potatoes
‘Sifra’ potatoes were observed and evaluated for disease incidence on day 21 post-inoculation at 25 °C (Figure 5). Potatoes exposed to UV-C treatment for 15 and 10 min had low disease incidence of 22% and 33%, respectively, compared to the pathogen control treatment, which had a 96% disease incidence. Notably, secondary infection by soft rot was observed in the pathogen control treatment (Figure 5A) on day 21 post-inoculation.

Figure 5.
Disease incidence of Fusarium dry rot on untreated (A), 10 min (B), and 15 min (C) UV-C treated ‘Sifra’ potatoes at 21 days post-inoculation at 25 °C, 95% RH.
3.4. SEM Analysis of the Interaction Between F. solani and UV-C Treatment
The interaction among UV-C, mycelia, and conidia of F. solani was observed under SEM after 7 days at 25 °C. Changes were observed in the mycelial structures of the pathogen treated with UV-C (Figure 6A,B) compared to the control (Figure 6C). Notably, UV-C treatment caused significant shrinkage, distortion, and breaking of the mycelia of F. solani (Figure 6A,B). The interaction between UV-C and F. solani was observed on the potato surface under SEM. The deposition of extracellular matrix (EM) was observed on the surface of UV-treated potatoes (Figure 7A,B). Micronidia of F. solani were observed in untreated potatoes (Figure 7C).

Figure 6.
Scanning electron microscopy images showing the mode of action by 10 min (A) and 15 min (B) of UV-C treatment on the mycelia compared to the untreated mycelia of Fusarium solani (C) grown on potato dextrose agar at day 7 post−inoculation at 25 °C. Yellow arrows show the breakage or distortion of mycelia (A,B) as well as hyphae (h) with round tips (rt) and macronidia (mc) of F. solani on a PDA plate (C).

Figure 7.
Scanning electron microscopy images showing the mode of action between Fusarium solani and UV-C irradiation at 10 min (A) and 15 min (B) on the potato surface, as well as the conidia (C) on the untreated potato surface after 14 days. Yellow arrows show deposition of extracellular matrix on potato surfaces (A,B) and macronidia of F. solani on potato surfaces (C).
4. Discussion
Ultraviolet-C (UV-C) irradiation is a cheap, safe, and convenient method for controlling postharvest pathogens during storage [17]. The potential of UVC irradiation (180–280 nm with maximum at λ = 254 nm) has been studied as an alternative to chemical fungicides to prevent postharvest diseases for horticultural crops [8,18,19]. The current study revealed that UV-C irradiation exhibited significant inhibitory effects against F. solani both in vitro and in vivo (Figure 4A,B and Figure 5B,C). In vivo studies indicated that UV-C treatment of potatoes for 10 min and 15 min suppressed the incidence of dry rot. The secondary infection by soft rot bacteria was also observed in untreated potatoes. The disease incidence caused by F. solani was reduced as the exposure time of potatoes to UV-C treatment was increased. These results are consistent with those obtained from the study of George et al. [20], which reported that UV-C treatment of wavelength 250 nm for 15 min minimized fruit decay, preserved sensory attributes, delayed ripening, and prolonged shelf life of ‘Chokanan’ mangoes stored at 4 °C for fifteen days. Similarly, GonzálezAguilar et al. [21] demonstrated that UV-C irradiation (8220 mW m-2 for 10 min) suppressed decay caused by microbial growth on ‘Tommy Atkins’ mango fruits after fifteen days of storage at 5 °C. The capacity of UV-C to reduce disease incidence in treated potatoes could be linked to its ability to activate β-1,3-glucanase and glucanohydrolase, which are pathogenesis-related proteins involved in disease resistance. UV-C may have elicited reactions in the tissue that inhibit the penetration and invasion of the fruit by the pathogen [22]. UV treatment can induce phytoalexin accumulation to a concentration inhibitory to the pathogen. In tomatoes, UV-C treatment was reported to induce accumulation of rishitin in UV-treated tomatoes, therefore increasing their resistance against B. cinerea [23]. Even though 5 min of UV-C treatment could not inhibit F. solani in the current study, the study of Romero et al. [24] reported a successful inhibition of Escherichia coli and Listeria innocua growth in ‘Tommy Atkins’ mango under a similar treatment duration. The inconsistency between these results may be because fungi have a more complex cell structure than bacteria and are much more resistant to germicidal UV-C [25]. Therefore, for fungal cells to be degraded, the exposure time of the pathogen to UV-C treatment should be increased.
The scanning electron micrographs revealed the morphological changes in the mycelia and conidia of F. solani treated with UV-C irradiation. The changes are characterized by shrinkage, breakage, and distortion of mycelia with rough surfaces in UV-C-treated samples. In comparison, normal growth of hyphae, thick with smooth surfaces, was observed in the control treatment. The spore production was also increased in untreated potatoes. These structural abnormalities suggest that UV-C irradiation disrupts the integrity of fungal cells. Mechanistically, such damage is likely the result of a combination of cellular stress responses. UV-C is known to induce DNA damage, particularly the formation of pyrimidine dimers, which interfere with replication and transcription processes [25]. Furthermore, UV-C exposure generates reactive oxygen species (ROS), which cause oxidative damage to cellular components, including lipids, proteins, and nucleic acids. The accumulation of ROS may lead to membrane destabilization, resulting in the shrinkage and surface deformation observed in the treated hyphae. Therefore, the ultrastructural changes seen under SEM likely reflect the combined effects of DNA damage, oxidative stress, and membrane disruption, which together compromise the viability and structural integrity of F. solani.
The deposition of plant extracellular matrix (ECM) was observed in UV-C-treated potato surfaces (Figure 7A,B). Although the observed plant ECM was not quantified in the current study, previous research reported that it acts as a physical barrier to prohibit the invasion of crops by microbial organisms such as fungi and bacteria [26]. The ECM of plants becomes involved in pathogen-induced defense responses in various ways. For instance, it reinforces the cell wall to hinder penetration of fungal pathogens that employ both mechanical force and digestion to initiate entry. This mechanism involves the deposition of lignin and callose [26,27], secretion of structural proteins [28], and oxidative crosslinking of existing proline-rich and hydroxyproline-rich glycoproteins [29]. Overall, these cell wall modifications increase the resistance of cells to digestion by microbial proteins [30,31].
The mode of action also involves the accumulation of antimicrobial compounds in the extracellular space. For instance, hydrogen peroxide (H2O2) can build up around invading pathogens, where it contributes to pathogen inhibition and disrupts infection processes [32,33]. In addition, cell wall–degrading enzymes such as chitinases and β-1,3-glucanases are released, targeting fungal structures and enhancing host resistance [32]. It has been reported that it directly kills the pathogen propagules and stops the invasion [33]. Furthermore, enzymes capable of degrading fungal cell walls, such as chitinases and b-1,3-glucanases [34], are released into the extracellular matrix. These enzymes can enhance fungal disease resistance in transgenic plants overexpressing these proteins [35]. In this study, UV-C treatment showed potential in inhibiting Fusarium dry rot in potatoes.
5. Conclusions
In this study, UV-C irradiation has proven to have antifungal properties against postharvest F. solani in potatoes. The mycelial growth of F. solani and the incidence of dry rot disease were significantly reduced by UV-C treatment. UV-C shows potential as a non-chemical control strategy but requires further optimization and validation under commercial conditions. Application of UVC may have some commercial challenges, including high costs, making it difficult for small-scale farmers to adopt. It also requires significant energy, increasing operational costs. Even though UV-C irradiation has provided successful control against several pathogens, its application may have some commercial challenges, including high costs, making it difficult for small-scale farmers to adopt. Further studies should incorporate quantitative severity assessments, including lesion size, rot depth, and visual scoring scales to provide a more comprehensive understanding of treatment performance and optimize UV-C application strategies. Additionally, future studies should also investigate the mode of action of UV-C irradiation against postharvest pathogens. The effect of UV-C on pathogenesis-related enzymes and proteins also warrants further investigation.
Author Contributions
N.C.M. and A.M. carried out the paper’s initial conceptualization and research design, G.B. conducted the research trials, data collection and the paper’s write-up, N.C.M. and A.M. reviewed and approved the paper before submission. All authors have read and agreed to the published version of the manuscript.
Funding
This research was funded by Potato South Africa (Potato Industry Development Trust), registration number 2005/034944/08.
Data Availability Statement
The datasets used or analyzed during the current study are available from the corresponding author upon reasonable request.
Conflicts of Interest
The authors declare no conflicts of interest.
References
- Stevenson, W.R. Compendium of potato diseases. Late blight. In Compendium of Potato Diseases, 2nd ed.; American Phytopathological Society: St. Paul, MN, USA, 2001; pp. 28–30. [Google Scholar]
- Ranjan, R.K.; Singh, D.; Rai, D. Postharvest Diseases of Potato and Their Management. In Postharvest Handling and Diseases of Horticultural Produce; CRC Press: Boca Raton, FL, USA, 2021; pp. 305–326. [Google Scholar]
- Wharton, P.; Hammerschmidt, R.; Kirk, W. Fusarium dry rot. In Michigan Potato Diseases Extension Bulletin; Michigan State University: East Lansing, MI, USA, 2007; pp. 213–221. [Google Scholar]
- Miller, J.S.; Olsen, N.; Woodell, L.; Porter, L.D.; Clayson, S. Postharvest applications of zoxamide and phosphite for control of potato tuber rots caused by oomycetes at harvest. Am. J. Potato Res. 2006, 83, 269–278. [Google Scholar] [CrossRef]
- Johnson, S.B. Postharvest applications of phosphorous acid materials for control of Phytophthora infestans and Phytophthora erythroseptica on potatoes. Plant Pathol. J. 2008, 7, 50–53. [Google Scholar] [CrossRef]
- Aktar, W.; Sengupta, D.; Chowdhury, A. Impact of pesticides use in agriculture: Their benefits and hazards. Interdiscip. Toxicol. 2009, 2, 1–12. [Google Scholar] [CrossRef] [PubMed]
- de Chaves, M.A.; Reginatto, P.; da Costa, B.S.; de Paschoal, R.I.; Teixeira, M.L.; Fuentefria, A.M. Fungicide resistance in Fusarium graminearum species complex. Curr. Microbiol. 2022, 79, 62. [Google Scholar] [CrossRef] [PubMed]
- Civello, P.M.; Vicente, A.R.; Martínez, G.A. UV-C technology to control postharvest diseases of fruits and vegetables. In Recent Advances in Alternative Postharvest Technologies to Control Fungal Diseases in Fruits and Vegetables; Transworld Research Network: Trivandrum, India, 2006; pp. 71–102. [Google Scholar]
- Terao, D.; de Carvalho Campos, J.S.; Benato, E.A.; Hashimoto, J.M. Alternative strategy on control of postharvest diseases of mango (Mangifera indica L.) by use of low dose of ultraviolet-C irradiation. Food Eng. Rev. 2015, 7, 171–175. [Google Scholar] [CrossRef][Green Version]
- Mditshwa, A.; Magwaza, L.S.; Tesfay, S.Z.; Mbili, N.C. Effect of ultraviolet irradiation on postharvest quality and composition of tomatoes: A review. J. Food Sci. Technol. 2017, 54, 3025–3035. [Google Scholar] [CrossRef] [PubMed]
- Bambalele, N.L.; Mditshwa, A.; Magwaza, L.S.; Tesfay, S.Z. Recent advances on postharvest technologies of mango fruit: A review. Int. J. Fruit Sci. 2021, 21, 565–586. [Google Scholar] [CrossRef]
- Ranganna, B.; Kushalappa, A.C.; Raghavan, G.S.V. Ultraviolet irradiance to control dry rot and soft rot of potato in storage. Can. J. Plant Pathol. 1997, 19, 30–35. [Google Scholar] [CrossRef]
- Stevens, C.; Khan, V.A.; Lu, J.Y.; Wilson, C.L.; Chalutz, E.; Droby, S.; Kabwe, M.K.; Haung, Z.; Adeyeye, O.; Pusey, L.P.; et al. Induced resistance of sweet potato to Fusarium root rot by UV-C hormesis. Crop Prot. 1999, 18, 463–470. [Google Scholar] [CrossRef]
- Liu, J.; Stevens, C.; Khan, V.A.; Lu, J.Y.; Wilson, C.L.; Adeyeye, O.; Kabwe, M.K.; Pusey, P.L.; Chalutz, E.; Sultana, T.; et al. Application of ultraviolet-C light on storage rots and ripening of tomatoes. J. Food Prot. 1993, 56, 868–873. [Google Scholar] [CrossRef] [PubMed]
- Liu, C.; Zheng, H.; Sheng, K.; Liu, W.; Zheng, L. Effects of UV-C treatment on the phenylpropanoid metabolism of postharvest peach fruit. Postharvest Biol. Technol. 2010, 56, 103–109. [Google Scholar]
- Guo, M.; Yang, R.; Chen, B.; Wang, F.; Qin, G.; Zhang, J. UV-C irradiation inhibits fungal growth and triggers DNA damage and oxidative stress in Aspergillus flavus. Front. Microbiol. 2021, 12, 658765. [Google Scholar]
- Allende, A.; Artés, F. Combined ultraviolet-C and modified atmosphere packaging treatments for reducing microbial growth of fresh processed lettuce. LWT-Food Sci. Technol. 2003, 36, 779–786. [Google Scholar] [CrossRef]
- Khubone, L.W.; Mditshwa, A. The effects of UV-C irradiation on postharvest quality of tomatoes (Solanum lycopersicum). Acta Hortic. 2017, 1201, 75–82. [Google Scholar] [CrossRef]
- Gumede, M.; Mditshwa, A.; Tesfay, S.; Magwaza, L.; Mbili, N. The effect of ozone and UV-C irradiation on strawberry postharvest quality. Acta Hortic. 2020, 1275, 15–22. [Google Scholar] [CrossRef]
- George, D.S.; Razali, Z.; Santhirasegaram, V.; Somasundram, C. Effects of ultraviolet light (UV-C) and heat treatment on fresh-cut Chokanan mango and Josephine pineapple quality. J. Food Sci. 2015, 80, S426–S434. [Google Scholar] [CrossRef] [PubMed]
- González-Aguilar, G.A.; Wang, C.Y.; Buta, J.G.; Krizek, D.T. Use of UV-C irradiation to prevent decay and maintain postharvest quality of ripe ‘Tommy Atkins’ mangoes. Int. J. Food Sci. Technol. 2001, 36, 767–773. [Google Scholar] [PubMed]
- Charles, M.T.; Tano, K.; Asselin, A.; Arul, J. Physiological basis of UV-C induced resistance to Botrytis cinerea in tomato fruit. V. Constitutive defence enzymes and inducible pathogenesis-related proteins. Postharvest Biol. Technol. 2009, 51, 414–424. [Google Scholar] [CrossRef]
- Charles, M.T.; Mercier, J.; Makhlouf, J.; Arul, J. Physiological basis of UVC-induced resistance to Botrytis cinerea in tomato fruit: I. Role of pre-and postchallenge accumulation of the phytoalexin-rishitin. Postharvest Biol. Technol. 2008, 47, 10–20. [Google Scholar] [CrossRef]
- Romero, L.; Colivet, J.; Aron, N.M.; Ramosvillarroel, A. Impact of ultraviolet light on quality attributes of stored fresh-cut mango. Ann. Univ. Dunarea Jos Galati. Fascicle VI Food Technol. 2017, 41, 62–80. [Google Scholar]
- Yin, R.; Dai, T.; Avci, P.; Jorge, A.E.S.; de Melo, W.C.M.A.; Vecchio, D.; Huang, Y.; Gupta, A.; Hamblin, M.R. Light based anti-infectives: Ultraviolet C irradiation, photodynamic therapy, blue light, and beyond. Curr. Opin. Pharmacol. 2013, 13, 731–762. [Google Scholar] [CrossRef] [PubMed]
- Chivasa, S.; Murphy, A.M.; Hamilton, J.M.; Lindsey, K.; Carr, J.P.; Slabas, A.R. Extracellular ATP is a regulator of pathogen defence in plants. Plant J. 2009, 60, 436–448. [Google Scholar] [CrossRef] [PubMed]
- Meyer, D.; Pajonk, S.; Micali, C.; O’cOnnell, R.; Schulze-Lefert, P. Extracellular transport and integration of plant secretory proteins into pathogen induced cell wall compartments. Plant J. 2009, 57, 986–999. [Google Scholar] [CrossRef] [PubMed]
- Smith, S.J.; Kroon, J.T.M.; Simon, W.J.; Slabas, A.R.; Chivasa, S. A novel function for Arabidopsis CYCLASE1 in programmed cell death revealed by isobaric tags for relative and absolute quantitation (iTRAQ) analysis of extracellular matrix proteins. Mol. Cell. Proteom. 2015, 14, 1556–1568. [Google Scholar] [CrossRef] [PubMed]
- Otte, O.; Barz, W. Characterization and oxidative in vitro cross-linking of an extensin-like protein and a proline-rich protein purified from chickpea cell walls. Phytochemistry 2000, 53, 1–5. [Google Scholar] [CrossRef] [PubMed]
- Haywood, V.; Kragler, F.; Lucas, W.J. Plasmodesmata: Pathways for protein and ribonucleoprotein signalling. Plant Cell 2002, 14, S303–S325. [Google Scholar] [CrossRef] [PubMed]
- Seifert, G.J.; Blaukopf, C. Irritable walls: The plant extracellular matrix and signaling. Plant Physiol. 2010, 153, 467–478. [Google Scholar] [CrossRef] [PubMed]
- Orozco-Cárdenas, M.L.; Narváez-Vásquez, J.; Ryan, C.A. Hydrogen peroxide acts as a second messenger for the induction of defense genes in tomato plants in response to wounding, systemin, and methyl jasmonate. Plant Cell 2001, 13, 179–191. [Google Scholar] [CrossRef] [PubMed]
- Walters, D. Resistance to plant pathogens: Possible roles for free polyamines and polyamine catabolism. New Phytol. 2003, 159, 109–115. [Google Scholar] [CrossRef] [PubMed]
- Ricci, P. Induction of the hypersensitive response and systemic acquired resistance by fungal proteins: The case of elicitins. In Plant-Microbe Interactions; Springer: Boston, MA, USA, 1997; pp. 53–75. [Google Scholar]
- Velasquez, L.A. The Pathogenesis Related Protein, Chitinase, and Its Role in the Systemic Acquired Resistance Phenotype in Cucumber Plants (Cucumis sativus L.). Ph.D. Thesis, Michigan State University, East Lansing, MI, USA, 2002. [Google Scholar]
Disclaimer/Publisher’s Note: The statements, opinions and data contained in all publications are solely those of the individual author(s) and contributor(s) and not of MDPI and/or the editor(s). MDPI and/or the editor(s) disclaim responsibility for any injury to people or property resulting from any ideas, methods, instructions or products referred to in the content. |
© 2025 by the authors. Licensee MDPI, Basel, Switzerland. This article is an open access article distributed under the terms and conditions of the Creative Commons Attribution (CC BY) license (https://creativecommons.org/licenses/by/4.0/).